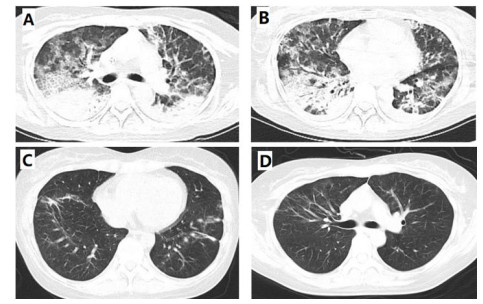

2. 中国医学科学院北京协和医学院,北京协和医院肾内科,疑难重症及罕见病国家重点实验室,100730 北京;
3. 中国医学科学院北京协和医学院,北京协和医院内分泌科,疑难重症及罕见病国家重点实验室,100730 北京
异位促肾上腺皮质激素(ectopic adrenocorticotropic hormone,EA)所致库欣综合征(cushing syndrome,CS)是一种由于垂体外占位性肿瘤异常分泌内源性皮质激素所引起的一系列临床综合征,常见病因有小细胞肺癌、胸腺瘤、支气管肿瘤、胰腺神经内分泌肿瘤等,其中,前纵隔类癌引起的EA少有报道[1],目前外源性糖皮质激素治疗导致肺部机会感染病例比较常见,但因为EA所致内源性促使体内皮质激素水平异常,免疫功能受损进而导致机会性感染,如病毒、卡式肺孢子菌肺炎等较为少见,有研究表明继发机会性感染也是影响EA患者的预后的因素之一[2],本文患者系前纵隔占位导致EA,术后继发卡氏肺孢子菌肺炎(pneumocystis carinii pneumonia,PCP), 经过复方磺胺甲恶唑(trimethoprim/sulfamethoxazole,TMP/SMX)等经验性治疗,诊疗过程及时有效,预后较好,特分享诊疗经验。
1 资料与方法病史及诊疗资料:31岁青年女性,体重增加1年,反复低钾、下肢水肿1月余,2019年9月(1年前)开始患者食欲增加,体重逐渐从45 kg增至56 kg,2020年7月(1月前)开始出现唇上小须,面部、颈部及上半身皮肤多发毛囊角化,双乳晕色深,掌纹不深,伴口干、多尿、多饮(约2 500 mL/d),乏力,双下肢浮肿。2020年7月12于外院检查发现:中重度低钾血症,24 h尿钾增多,皮质醇水平、24 h游离尿皮质醇升高,血皮质醇节律消失,小剂量地塞米松试验未被抑制,睾酮水平升高,肝肾功、余垂体功能及甲功大致正常,肿标:CYFRA21-1 7.74 ng/mL(0~3.3),CA72-4 16.89 U/mL(0~6.9),Ferritin 168.6 ng/mL(13~150),AFP、CEA、CA125、CA19-9、CA15-3(-)。影像学,CT: 前纵隔结节,肿瘤可能,双侧肾上腺增粗。增强CT:前纵隔结节,余无感染病灶。垂体MRI平扫+增强:未见异常。监测血压在正常范围内,诊断为“异位ACTH综合征”,予口服补钾等对症,下肢水肿、乏力等无明显缓解。2020-7-27于外院FDG-PET-CT:双侧肾上腺代谢增高,考虑增生改变(SUVmax=17.0),前纵隔结节,直径1.8 cm,代谢未见明显增高。2020年8月4日(4 d前)于本院门诊就诊,查24 h UFC 3 033.5 μg,ACTH(8AM) 980.0 pg/mL,血F > 75.00 μg/dL,K 2.4 mmol/L,Glu 6.3 mmol/L,肾功正常范围内。68Ga-DOTATATE PET-CT示:①前纵隔可见一中度放射性摄取增高灶,大小约为1.8 cm×1.6 cm,SUVmax约为6.7,结合病史,不除外异位ACTH瘤;②甲状腺双叶可见多发低密度小结节,放射性摄取较正常甲状腺组织低;③左侧肾上腺明显增粗,放射性摄取增高,SUVmax约为11.0;予螺内酯片20 mg(3次/d)、枸橼酸钾溶液10% 20 mL(3次/d)口服,近日下肢水肿较前减轻,但仍有乏力。病程中,患者情绪低落,精神差,记忆力减退,偶有心悸,食欲正常,睡眠欠佳,二便尚可。
既往史:2019年8月因头晕外院诊断“前庭神经炎”,应用糖皮质激素(甲强龙40-60 mg/d)约1周好转,之后未再应用糖皮质激素。2019年12月使用“颜如玉”,每天1瓶,连续服用2月。住院期间诊断糖尿病,服用伏格列波糖片0.2 mg(3次/d)治疗。婚育史:25岁结婚,2018年2月离异,有1女,5.5岁,身体健康。月经史:初潮13岁,行经天数5~7 d,月经周期28~30 d。近3月月经不规律,每次提前10 d来潮,持续10 d左右,经量少,发黑,近1月月经未潮,末次月经2020年7月28日。个人史家族史无殊。查体:BP 124/89 mmHg,Wt 56 kg,Ht 162 cm,BMI 21.34 kg/m2,腰围73 cm,脸圆,下颌、颈部、躯干部可见多发毛囊角化、痤疮,双侧上肢肘窝可见瘀斑,锁骨上脂肪垫(+),唇上小须,双足轻度凹陷性水肿。入院诊断:ACTH依赖性库欣综合征;异位ACTH综合征可能性大;前纵隔占位;重度低钾血症。
第一次收住院诊疗经过:完善常规生化提示低钾血症、高脂血症,超声心动图:微量心包积液,EF67%。肺通气功能正常。库欣综合征定性定位诊断方面,血总皮质醇(血F)(8AM) 69.6 μg/dL, ACTH(8AM) 664.0 pg/mL, 24 h尿游离皮质醇(24HUFC)2 723.2 μg/24 h,大剂量地塞米松抑制试验(见表 1); 标筛查:AFP 4.6 ng/mL, CA19-9 22.2 U/mL, CEA 3.0 ng/mL, CA125 38.4 U/mL, 细胞角蛋白19片段Cyfra211 6.0 ng/mL, CA242 19.0 U/mL, CA72-4 8.6 U/mL, CA15-3 12.9 U/mL, ProGRP 26.0 pg/mL, NSE 15.4 ng/mL。生长抑素受体显像:前纵隔结节,生长抑素受体高表达灶,考虑神经内分泌肿瘤可能性大;双侧肾上腺增生。(图 1C);垂体平扫+动态增强MRI:垂体后叶短T1信号存在垂体左翼强化减低区,考虑微腺瘤。胸增强CT:前纵隔占位,结合病史,不除外异位ACTH瘤(图 1A);TB细胞亚群11项: %memory T4 78.1%, B% 17.9%, T4% 17.6%, T8% 42.1%, RAT4% 21.9%, NaT4% 21.7%, 28T8% 32.1%, DRT 8% 76.2%, 38T8% 83.0%, T4/T8 0.42%, 垂体前叶功能,甲功1:TSH 0.077 μIU/mL, FT4 1.73 ng/dl, FT3 2.17 pg/mL, GH < 0.05 ng/mL, IGF1 132 ng/mL。FSH 2.13 IU/L, LH 0.26 IU/L, E2(Ⅱ) < 15 pg/mL, T 1.96 ng/mL, PRL 6.9 ng/mL, P 5.31 ng/mL。MEN筛查,GASTRIN 260 pg/m,ProGRP 23.9 pg/mL。降钙素(CT) < 1.5 pg/mL,钙素原PCT 0.23 ng/mL, CK 33 U/L。IPSS+DDAVP兴奋试验示基线时中枢和外周ACTH无梯度(见表 2),结合大剂量地塞米松抑制实验不被抑制,支持异位ACTH综合征,考虑胸腺占位为责任病灶可能。治疗方面,入院后予口服及静脉补钾、螺内酯纠正低钾血症,监测血糖,餐后2 h血糖高,给予胰岛素及口服降糖药后血糖基本达标。患者前纵隔结节考虑为异位ACTH瘤可能大,2020-08-26行VATS胸腺及肿瘤切除术,术后恢复良好,激素替代方案由围术期静脉应用琥珀酸氢化可的松逐渐过渡为醋酸氢化可的松片早40 mg,晚20 mg替代治疗后出院(图 3主要指标趋势及用药情况)。2020-08-31无明显诱因出现发热,体温最高达39℃,当地诊所静点“头孢类抗生素”、口服布洛芬治疗2 d,仍间断发热,并出现站立后头晕,当时血压76/40 mmHg,就诊当地医院,查血常规:WBC 6.01×109/L, NEUT% 85.2%, LYM% 13%; CRP 194.74 mg/L; CMV DNA阳性;胸部CT提示双肺弥漫渗出,考虑“重症肺炎I型呼吸衰竭”于当地重症监护室予以“无创呼吸机辅助呼吸,哌拉西林他唑巴坦、奥司他韦、伏立康唑抗感染,丙种球蛋白免疫支持”。治疗效果欠佳,胸闷、憋气逐渐加重,伴咳少许白色黏痰。2020-09-03就诊本院,考虑重症肺炎收入急诊重症监护病房,第2次收住院诊疗经过:呼吸方面:复查胸CT提示:双肺弥漫炎性改变,双侧胸腔积液并左下肺轻度膨胀不全(图 2A 、B)。予高流量氧疗支持,完善肺泡灌洗液: PCP DNA阳性(+),CMV(+),结合病史、症状、体征及辅助检查证据,考虑肺孢子菌肺炎、巨细胞病毒肺炎、混合细菌感染,头孢他啶1 g/8 h、莫西沙星0.4 g/d、TMP/SMX 3片3次/d,更昔洛韦0.25 g/8 h,呼吸困难逐渐改善,复查CT病灶明显吸收(图 2C 、D)。内分泌方面:考虑EA导致CS术后,激素替代治疗中合并机会性感染,调整治疗:停用口服,给予琥珀酸氢化可的松50 mg/6 h。口服降糖药控制类固醇糖尿病,口服碳酸钙片治疗骨质疏松。原发病方面:结合病理胸腺病灶考虑内分泌来源类癌,恶性程度低,无需放化疗。2020-09-30出院时患者无发热、头晕、纳差、恶心、呕吐、电解质紊乱、低血糖等肾上腺皮质功能不全表现,氢化可的松早40 mg-午20 mg逐渐减量(图 3主要指标趋势及用药情况),激素替代期间TMP/SMX 2片/d预防感染,门诊随诊。

|
| A:纵隔窗白色箭头提示前纵隔占位1.8×1.6cm;B:肺窗未提示感染感染;C:99mTc-HTOC:前纵隔结节,生长抑素受体高表达灶 图 1 8-13胸部增强CT |
|
|
| 时间 | 0 min | 3 min | 5 min | 10 min |
| 外周血 | 1 053 | > 1 250 | > 1 250 | > 1 250 |
| 左岩下 | 1 096 | > 1 250 | > 1 250 | > 1 250 |
| 右岩下 | 1 203 | > 1 250 | > 1 250 | > 1 250 |
| 左颈内 | 1 094 | |||
| 右颈内 | 1 120 |
|
| 图 2 9-4 A、B双肺间质弥漫性渗出伴炎性改变,双下肺实变影9-16 C、D治疗后复查双肺炎性改变较前明显改善 |
|
|

|
| 图 3 血促肾上腺皮质激素(ACTH)、血总皮质醇(serum F)、24 h尿皮质醇(24UF)、淋巴细胞绝对值(lymphocyte)、中性粒细胞绝对值(neutrophile)、血清钾离子水平(serum potassium)趋势及螺内酯(spironolactone)、氢化可的松(hydrocortisone)的用量关系图 |
|
|
CS最早于1932年由Harvey Cushing提出,是由于内源性或外源性原因所致的体内皮质醇水平升高,继而发生血压、血糖异常、皮肤改变、肥胖、骨质疏松等,亦可使免疫系统功能失调,巨噬细胞及中性粒细胞分化迁移能力变差,下调促炎细胞因子水平,从而使机体易继发机会感染如真菌、结核、巨细胞病毒等[3]。
2.2 本例患者的诊疗要点有哪些?定位定性诊断:患者首次入院既表现为高皮质醇血症的体貌(包括脸圆、痤疮、锁骨上脂肪垫、唇上小须等),同时伴有双下肢浮肿及持续的中-重度低钾血症。结合辅助检查特点血皮质醇水平、24 h游离尿皮质醇升高,血皮质醇节律消失,小剂量地塞米松试验未被抑制,考虑库欣综合征定性诊断明确。定位诊断方面,患者外院和本院查血尿皮质醇显著升高的同时ACTH不被抑制,符合ACTH依赖的CS,结合大剂量地塞米松抑制试验未被抑制,垂体动态增强核磁未见明显异常,奥曲肽显像、99mTc-HTOC等影像学均提示前纵隔结节生长抑素高摄取,考虑异位ACTH综合征明确,犯罪病灶在前纵隔,本病常见于异位肿瘤分泌促肾上腺皮质激素,如肺癌、胸腺瘤、支气管类癌、消化道和卵巢肿瘤等,通常病情进展快,ACTH升高明显,往往存在严重低血钾、代谢性碱中毒等。
原发病治疗:异位ACTH最佳治疗方案为手术切除肿瘤,从而去除ACTH来缘,Isidori等[4]报道的26例肺类癌患者中10例在切除肿瘤后病情缓解,9例局限性神经内分泌肿瘤或其他类癌患者中有8例在切除肿瘤后获得缓解对于肿瘤无法切除的患者可使用肾上腺酶抑制剂来控制皮质醇增多症,如酮康唑、美替拉酮和依托咪酯等,可以通过抑制一种或多种皮质醇合酶发挥作用。本例患者经过术前评估,符合可切除肿瘤,结合图 3 ACTH变化趋势可以看出,原发病方面手术效果良好,但围手术期的激素替代方案需要充分的经验及密切的监测才能避免出现皮质功能不全甚至肾上腺危象的出现。
并发症评估处理:该患者目前突出的表现为中-重度低钾血症,考虑为大量皮质醇激动盐皮质激素受体所致。密切监测血钾,积极纠正低钾血症,警惕低钾血症所致的心律失常、横纹肌溶解。患者首次住院期间出现严重低钾血症,经过大量的口服及静脉补钾增加钾的摄入,螺内酯保利尿剂增加钾的重吸收,具体剂量及治疗反映详见图 3,是保障患者尽快诊断及治疗的重点难点所在。皮质醇血症可导致糖脂代谢、水盐平衡异常,可通过监测血糖、HbA1c、糖化白蛋白、容量管理等动态调整,有研究表明,液体负平衡可降低重症肺炎患者病死率[5]。钙磷代谢方面,长期高皮质醇血症可促进尿钙排泄、抑制肠钙吸收,导致继发性骨质疏松,因此骨密度、胸腰椎正侧位等检查及积极补钙等治疗是预防骨质疏松防止骨折的关键。通过完整的定性定位检查及手术病理证实为前纵隔类癌的EA所致CS,整个病程相对较长,虽手术过程顺利,但术后激素替代过程中很快出现了机会感染,结合图 3趋势不难发现,患者术后ACTH及血F水平急剧下降,淋巴细胞绝对值也低于正常下限,当内源性激素水平迅速下降的同时,外源性激素补充不及时可能出现皮质功能不全表现,且患者体内长期处于高皮质醇水平,加之手术打击,再次发热后迅速出现多种机会病原体感染,PCP及巨细胞病毒(cytomegalovirus,CMV),内环境紊乱、皮质功能不全进展为休克,病情危重,病死率极高,因此,机会性感染的早期识别、合理的抗感染方案及容量管理策略至关重要[6]。
2.3 为什么药物控制或手术切除肿瘤后患者容易发生机会性感染?Arlt, A报道的右肾神经内分泌肿瘤患者在接受甲吡酮和氢化可的松治疗,皮质醇水平下降后肺泡灌洗液发现PCP,虽加用预防性复方磺胺甲恶唑治疗仍迅速进展为呼吸衰竭死亡[7],Graham等[8]曾报道6例内源性库欣综合征合并机会性感染,感染风险与皮质醇水平相关,Sarlis等[9]回顾性分析发现,当皮质醇水平下降过程中继发重症PCP感染,可能与氢化可的松的抗炎作用减低有关;van Halem等[10]系统回顾了库欣合并PCP感染患者,发现在开始应用肾上腺抑制剂如酮康唑、米托坦或糖皮质激素受体拮抗剂如米非司酮等治疗使皮质醇水平下降时,在激素替代的免疫重建过程中也容易继发PCP等机会感染,Hasenmajer等[11]在近期的一篇库欣综合征与免疫的综述中提到,当通过药物或手术使患者库欣得到缓解时,患者体内淋巴细胞计数会随之下降,可能与过程中影响骨髓造血、细胞因子变化及免疫细胞凋亡相关,进而使机会感染风险增加,这点与本文患者表现一致(图 3)。另文献报道,当24 h尿UFC超过5倍上限或血皮质醇水平超出正常上限20倍时,或者治疗后存在激素水平急剧下降时,此时建议经验性加用复方磺胺甲恶唑预防机会性感染[12]。
2.4 如何监测及预防?关注手卫生,免疫抑制状态患者需要坚持佩戴口罩,密切监测血淋巴细胞计数、外周血淋巴细胞亚群、G试验、LDH等,一旦出现发热、干咳、呼吸困难等症状,尽快收集呼吸道感染的病原学证据,因为继发PCP感染导致呼吸衰竭病死率极高,是不良预后的关键因素[10]。
综上所述,EA所致CS合并PCP感染,起病隐匿,病情危重,严重影响患者预后,常规指南并未明确推荐预防PCP的治疗时机及方案[13],但结合以往相关报道不难发现,密切监测及经验性预防PCP感染是改善预后的关键所在,5倍上限的FUC和20倍上限的血总皮质醇水平以及经过治疗后皮质醇水平急剧变化时可以作为预防PCP感染的干预时机。
利益冲突 所有作者声明无利益冲突
| [1] | Oda N, Miyahara N, Tabata M, et al. Pneumocystis pneumonia concomitant with ectopic ACTH syndrome caused by a large cell neuroendocrine carcinoma of the Thymus[J]. Intern Med, 2017, 56(5): 551-555. DOI:10.2169/internalmedicine.56.7655 |
| [2] | Sarlis NJ, Chanock SJ, Nieman LK. Cortisolemic indices predict severe infections in Cushing syndrome due to ectopic production of adrenocorticotropin[J]. J Clin Endocrinol Metab, 2000, 85(1): 42-47. DOI:10.1210/jcem.85.1.6294 |
| [3] | Scheffel RS, Dora JM, Weinert LS, et al. Invasive fungal infections in endogenous Cushing's syndrome[J]. Infect Dis Rep, 2010, 2(1): e4. DOI:10.4081/idr.2010.e4 |
| [4] | Isidori AM, Kaltsas GA, Pozza C, et al. The ectopic adrenocorticotropin syndrome: clinical features, diagnosis, management, and long-term follow-up[J]. J Clin Endocrinol Metab, 2006, 91(2): 371-377. DOI:10.1210/jc.2005-1542.4 |
| [5] | 朱轶, 张忠满, 邓晴, 等. 液体负平衡对重症肺炎患者预后的影响[J]. 中华急诊医学杂志, 2020, 29(8): 1053-1058. DOI:10.3760/cma.j.issn.1671-0282.2020.08.006 |
| [6] | 汪华玲, 陈齐红. 感染性休克液体管理策略: 少即是多[J]. 中华急诊医学杂志, 2020, 29(11): 1502-1504. DOI:10.3760/cma.j.issn.1671-0282.2020.11.026 |
| [7] | Arlt A, Harbeck B, Anlauf M, et al. Fatal Pneumocystis jirovecii pneumonia in a case of ectopic Cushing's syndrome due to neuroendocrine carcinoma of the kidney[J]. Exp Clin Endocrinol Diabetes, 2008, 116(9): 515-519. DOI:10.1055/s-2008-1062729 |
| [8] | Graham BS, Tucker WS Jr. Opportunistic infections in endogenous Cushing's syndrome[J]. Ann Intern Med, 1984, 101(3): 334-338. DOI:10.7326/0003-4819-101-3-334 |
| [9] | Sarlis NJ, Chanock SJ, Nieman LK. Cortisolemic indices predict severe infections in Cushing syndrome due to ectopic production of adrenocorticotropin[J]. J Clin Endocrinol Metab, 2000, 85(1): 42-47. DOI:10.1210/jcem.85.1.6294 |
| [10] | van Halem K, Vrolijk L, Pereira AM, et al. Characteristics and mortality of Pneumocystis pneumonia in patients with cushing's syndrome: a plea for timely initiation of chemoprophylaxis[J]. Open Forum Infect Dis, 2017, 4(1): ofx002. DOI:10.1093/ofid/ofx002 |
| [11] | Hasenmajer V, Sbardella E, Sciarra F, et al. The immune system in cushing's syndrome[J]. Trends Endocrinol Metab, 2020, 31(9): 655-669. DOI:10.1016/j.tem.2020.04.004 |
| [12] | Gabalec F, Zavrelová A, Havel E, et al. Pneumocystis pneumonia during medicamentous treatment of Cushing's syndrome: a description of two cases[J]. Acta Medica (Hradec Kralove), 2011, 54(3): 127-130. DOI:10.14712/18059694.2016.35 |
| [13] | Nieman LK, Biller BMK, Findling JW, et al. Treatment of cushing's syndrome: an endocrine society clinical practice guideline[J]. J Clin Endocrinol Metab, 2015, 100(8): 2807-2831. DOI:10.1210/jc.2015-1818 |
 2023, Vol. 32
2023, Vol. 32




